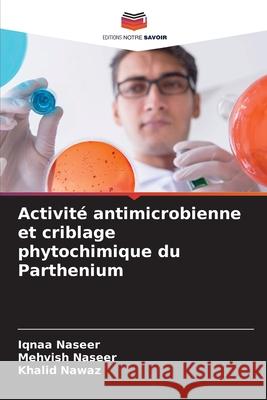
Activité antimicrobienne et criblage phytochimique du Parthenium Naseer, Iqnaa, Naseer, Mehvish, Nawaz, Khalid 9786209275951 Editions Notre Savoir - książka

Activité antimicrobienne et criblage phytochimique du Parthenium » książka
Activité antimicrobienne et criblage phytochimique du Parthenium
ISBN-13: 9786209275951 / Francuski / Miękka / 2025 / 80 str.
Les propriétés curatives des plantes sont dues à la présence de métabolites secondaires qui agissent comme des armes pour protéger le corps végétal contre les organismes nuisibles. On suppose que le Parthenium hystrophours possède une activité antibactérienne et antifongique convaincante. La présente étude a donc été menée afin de déterminer l'activité antibactérienne et antifongique de cette plante et de procéder à un criblage phytochimique préliminaire. La plante étudiée a été traitée avec trois solvants, à savoir le méthanol, l'éthanol et l'eau, après avoir été réduite en poudre afin de préparer des extraits organiques végétaux. L'activité antibactérienne a été déterminée à l'aide d'un test de diffusion en puits contre douze souches bactériennes : Escherichia coli 1, Escherichia coli 2, Escherichia coli 3, Neisseria gonorrhoeae, Streptococcus pyogenes, Enterobactor aerogenes, Shigella sonnei, Micrococcus luteus, Bacillus subtilis, Staphylococcus aureus 1, Staphylococcus aureus 2 et Klebsiella pneumonia. Un paramètre très novateur a également été appliqué, qui concernait l'effet du temps sur les doses d'extrait pour inhiber la croissance bactérienne afin de déterminer l'efficacité des médicaments bruts à base de plantes.